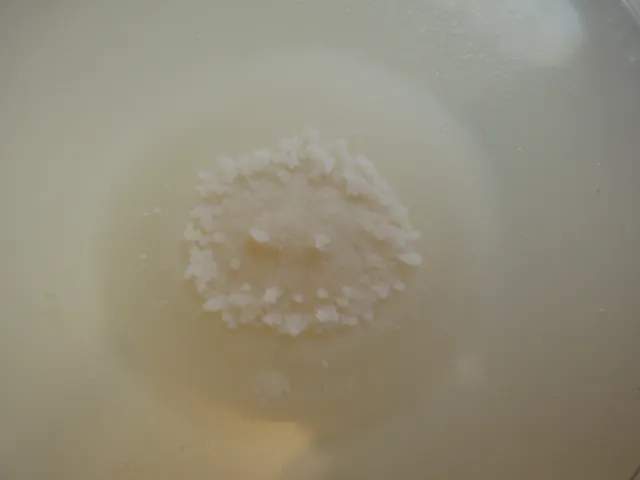

Navn og taksonomi
- Vitenskapelig navn:
- Lachnum virgineum (Batsch: Fr.) P. Karst.
- Synonymer:
- Dasyscyphus virgineus (Batsch: Fr.) Gray, Peziza virginea Batsch
- Bokmål:
- Ingen
- Nynorsk:
- Ingen
- Nordsamisk/Davvisámegiella:
- Ingen
- Vitenskapelig navn ID:
- 67848
- Takson ID:
- 43821
Kategori
Fastlands-Norge
NE
Ikke vurdert
Registrerte funn i Norge
‐
Funn totalt
‐
Funn denne uken
‐
Funn i dag

Bilder
Siden siteres som
Artsdatabanken: Lachnum virgineum (Batsch: Fr.) P. Karst.
Hentet fra https://artsdatabanken.no/arter/takson/43821